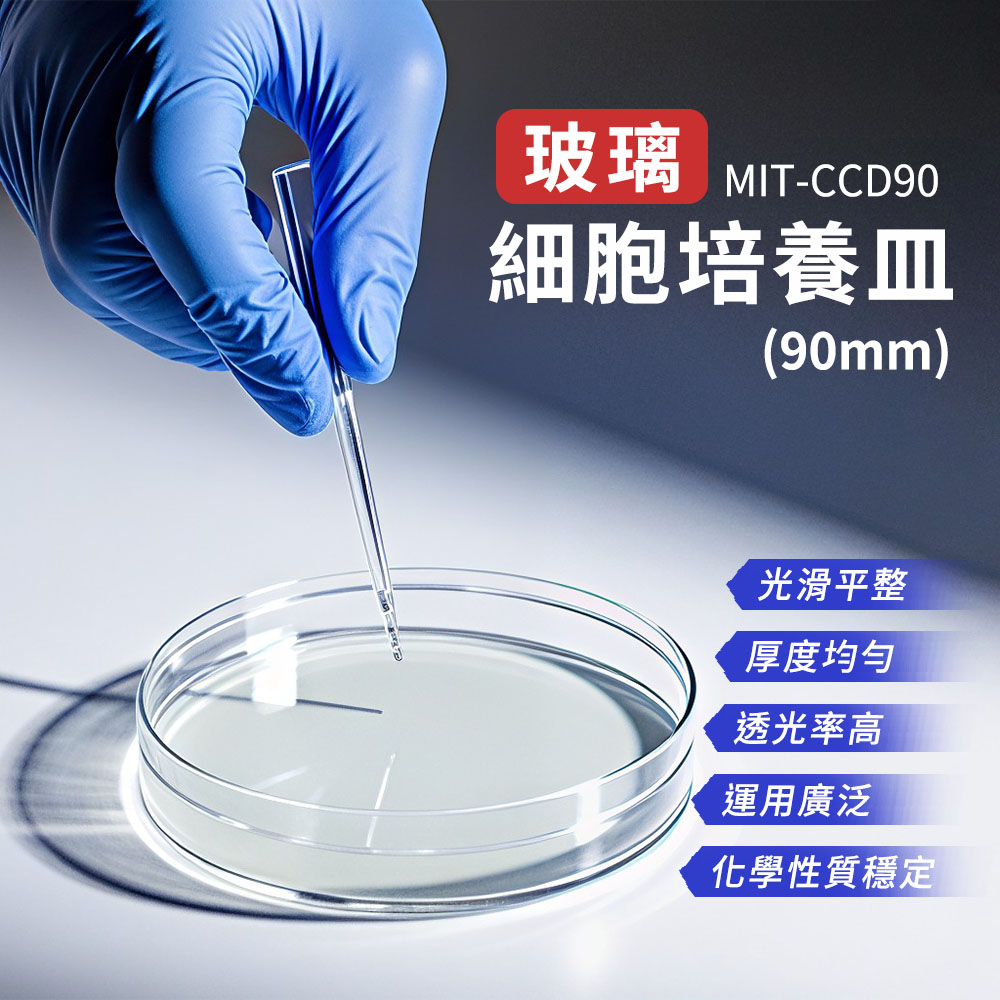

MIT-CCD90_玻璃細胞培養皿(90mm)
MIT-CCD90_玻璃細胞培養皿(90mm)
皿底平整、厚度均一,利於均勻鋪平培養基與準確測量,可勝任複雜的過濾、分餾、提取作業,滿足精密分離與萃取需求。
高透明度便於觀察菌落形態、邊緣、生長界線與色澤變化,良好耐化學性對酸、鹼、酒精、多數有機溶劑具穩定性,不易被培養基或消毒劑侵蝕、染色。
‒ 高透明度、低失真
‒ 良好耐化學性
‒ 可高溫滅菌、重複使用
‒ 皿底平整、厚度均一
適用化驗室、科研機構、院校、實驗室與製藥廠…等
產品名稱:MIT-CCD90_玻璃細胞培養皿(90mm)
材質:高硼硅
外徑:90mm
內徑:87mm
重量:45g
尺寸:90mm* h18mm
【產品尺寸為單批測量,每批製造可能略有誤差,請以實際收到商品為準。】
皿底平整、厚度均一,利於均勻鋪平培養基與準確測量,可勝任複雜的過濾、分餾、提取作業,滿足精密分離與萃取需求。
高透明度便於觀察菌落形態、邊緣、生長界線與色澤變化,良好耐化學性對酸、鹼、酒精、多數有機溶劑具穩定性,不易被培養基或消毒劑侵蝕、染色。
‒ 高透明度、低失真
‒ 良好耐化學性
‒ 可高溫滅菌、重複使用
‒ 皿底平整、厚度均一
適用化驗室、科研機構、院校、實驗室與製藥廠…等
產品名稱:MIT-CCD90_玻璃細胞培養皿(90mm)
材質:高硼硅
外徑:90mm
內徑:87mm
重量:45g
尺寸:90mm* h18mm
【產品尺寸為單批測量,每批製造可能略有誤差,請以實際收到商品為準。】
NT$37
商品編號:
MIT-CCD90
加入最愛
此商品 「 最高 」可以折抵紅利
0
點
(約等於 NT$0 )